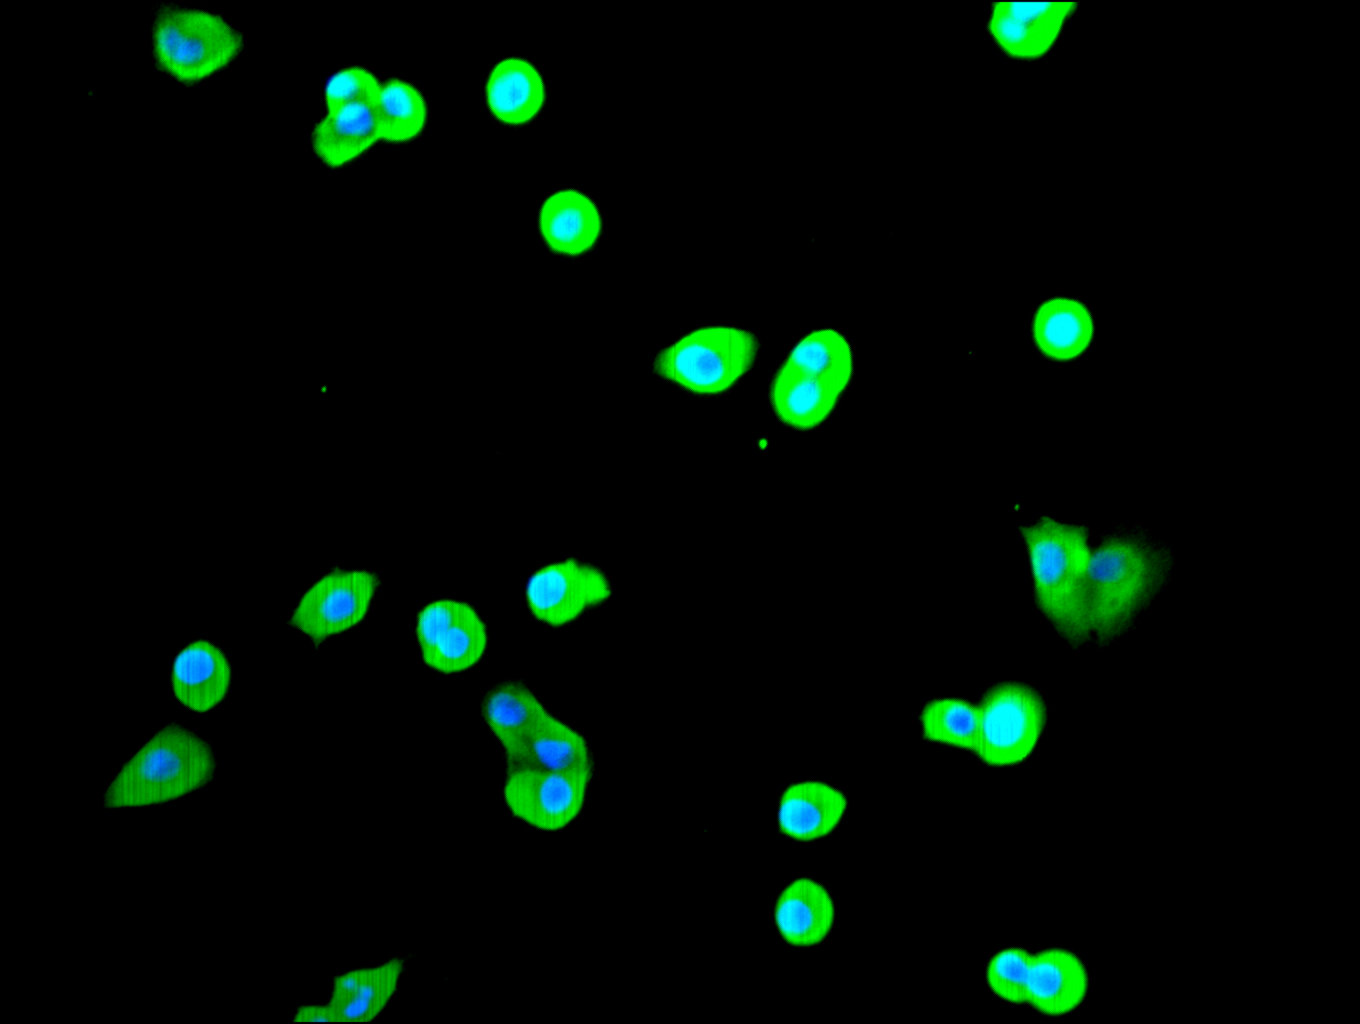

-
中文名稱:RRM2 Recombinant Monoclonal Antibody
-
貨號:CSB-RA020519MA1HU
-
規格:¥1320
-
圖片:
-
Western Blot
Positive WB detected in: A-431 whole cell lysate(30μg)
All lanes: RRM2 antibody at 1:1000
Secondary
Goat polyclonal to human IgG at 1/40000 dilution
Predicted band size: 45 kDa
Observed band size: 45 kDa
Exposure time: 5min -
Immunofluorescence staining of Hela cell with CSB-RA020519MA1HU at 1:30 ,counter-stained with DAPI. The cells were fixed in 4% formaldehyde, permeabilized using 0.2% Triton X-100 and blocked in 10% normal Goat Serum. The cells were then incubated with the antibody overnight at 4°C. The secondary antibody was Fluorescein (FITC) AffiniPure Goat Anti-Human IgG, Fcγ fragment specific.
-
Immunofluorescence staining of HepG2 cell with CSB-RA020519MA1HU at 1:30 ,counter-stained with DAPI. The cells were fixed in 4% formaldehyde, permeabilized using 0.2% Triton X-100 and blocked in 10% normal Goat Serum. The cells were then incubated with the antibody overnight at 4°C. The secondary antibody was Fluorescein (FITC) AffiniPure Goat Anti-Human IgG, Fcγ fragment specific.
-
Overlay Peak curve showing jurkat cells stained with CSB-RA020519MA1HU (red line) at 1:100. The cells were fixed in 4% formaldehyde and permeated by 0.2% TritonX-100 for 10min. Then 10% normal goat serum to block non-specific protein-protein interactions followed by the antibody (1ug/1*106cells) for 45min at 4℃. The secondary antibody used was Fluorescein (FITC) AffiniPure Goat Anti-Human IgG, Fcγ fragment specific at 1:200 dilution for 35 min at 4℃.Control antibody (green line) was human IgG1 (1ug/1*106cells) used under the same conditions. Acquisition of >10,000 events was performed.
-
-
其他:
產品詳情
-
Uniprot No.:
-
基因名:
-
別名:cb111 antibody; chunp6884 antibody; etID309896.20 antibody; R2 antibody; reductase M2 polypeptide variant 1 antibody; reductase M2 polypeptide variant 2 antibody; reductase M2 polypeptide variant 3a antibody; reductase M2 polypeptide variant 3b antibody; reductase M2 polypeptide variant 3c antibody; reductase M2 polypeptide variant 3d antibody; Ribonucleoside-diphosphate reductase subunit M2 antibody; Ribonucleotide reductase M2 antibody; Ribonucleotide reductase M2 polypeptide antibody; Ribonucleotide reductase M2 subunit antibody; ribonucleotide reductase protein r2 class I antibody; Ribonucleotide reductase regulatory subunit M2 antibody; Ribonucleotide reductase small chain antibody; Ribonucleotide reductase small subunit antibody; Ribonucleotide reductase, R2 subunit antibody; RIR2_HUMAN antibody; RR2 antibody; RR2M antibody; RRM2 antibody
-
反應種屬:Human
-
免疫原:Recombinant Human RRM2 protein
-
免疫原種屬:Homo sapiens (Human)
-
標記方式:Non-conjugated
-
克隆類型:Monoclonal
-
抗體亞型:hIgG1
-
純化方式:Affinity-chromatography
-
克隆號:14F4
-
濃度:It differs from different batches. Please contact us to confirm it.
-
保存緩沖液:Preservative: 0.03% Proclin 300
Constituents: 50% Glycerol, 0.01M PBS, PH 7.4 -
產品提供形式:Liquid
-
應用范圍:ELISA, WB, IF, FC
-
推薦稀釋比:
Application Recommended Dilution WB 1:500-1:2000 IF 1:50-1:200 FC 1:50-1:200 -
Protocols:
-
儲存條件:Upon receipt, store at -20°C or -80°C. Avoid repeated freeze.
-
貨期:Basically, we can dispatch the products out in 1-3 working days after receiving your orders. Delivery time maybe differs from different purchasing way or location, please kindly consult your local distributors for specific delivery time.
-
用途:For Research Use Only. Not for use in diagnostic or therapeutic procedures.
相關產品
靶點詳情
-
功能:Provides the precursors necessary for DNA synthesis. Catalyzes the biosynthesis of deoxyribonucleotides from the corresponding ribonucleotides. Inhibits Wnt signaling.
-
基因功能參考文獻:
- Cyclin F and ribonucleotide reductase family member 2 (RRM2) compose a functional axis responsible for nucleotide metabolism. Impairment in this pathway may contribute to increased DNA damage repair and drug resistance. Additionally, we analyzed the expression of RRM2 mRNA and discovered that high expression of RRM2 is associated with worse overall survival. PMID: 29767233
- overexpression of RRM2 is associated with the genesis and progression of neuroblastoma, and may be a potential chemotherapeutic target PMID: 29749541
- Data suggest that targeting of breast cancer 1, early onset protein (BRCA1)-ribonucleotide reductase regulatory subunit M2 (RRM2) axis may represent a paradigm for therapeutic intervention in glioblastoma (GBM). PMID: 27845331
- These results demonstrate that gambogic acid sensitizes pancreatic cancer cells to gemcitabine in vitro and in vivo by inhibiting the activation of the ERK/E2F1/RRM2 signaling pathway. PMID: 28797284
- OX2 and RRM2 are suggested to be prominent markers for breast cancer metastasis. PMID: 28782484
- SLFN11 contributes to the sensitivity of Ewing sarcoma cells to inhibition of ribonucleotide reductase M2 PMID: 27557498
- Results indicate CREB1 as a critical transcription factor of RRM2 which promotes tumor aggressiveness, and imply a significant correlation between CREB1 and RRM2 in CRC specimens. PMID: 27801665
- These findings suggest that the identified APLP2, RRM2, and PRC1 signature could be useful for distinguishing between benign (follicular adenoma) and malignant (follicular carcionma and follicular variant of papillary carcinoma) tumors of the thyroid follicular epithelium. PMID: 27796194
- Data show that inhibition of sphingosine kinase-2 by ABC294640 is synergistically cytotoxic with gemcitabine toward three pancreatic cancer cell lines, resulting in decreased expression of both ribonucleotide reductase regulatory subunit M2 (RRM2) and c-MYC protein (Myc) in all three cell lines. PMID: 27517489
- Here we designed UC-rich and CU-rich 10-nt sequences for engagement of both RRM2 and RRM3 and demonstrated that the TIA-1 RRM23 construct preferentially binds the UC-rich RNA ligand. Together our data support a specific mode of TIA-1 RRM23 interaction with target oligonucleotides consistent with the role of TIA-1 in binding RNA to regulate gene expression PMID: 28184449
- These data suggest that VASH2 reduces the chemosensitivity to gemcitabine in pancreatic cancer cells via JUN-dependent transactivation of RRM2. PMID: 28327155
- HPV31 regulates RRM2 levels through expression of E7 and activation of the ATR-Chk1-E2F1 DNA damage response, which is essential to combat replication stress upon entry into S-phase. PMID: 27764728
- To the best of our knowledge, this is the first study that investigated the relationship of RRM1 and RRM2 gene polymorphisms and Coronary artery disease (CAD). PMID: 27566080
- The SCYL1- BP1 affects the cell cycle through increasing steady state levels of Cyclin F and RRM2 proteins, thus constituting a dual regulatory circuit. PMID: 25980818
- A significant association has been found between RRM2 rs6759180 (located in the 5'UTR, 10126436G>A) and the risk for developing non-small cell lung cancer. PMID: 26718430
- Data show that ribonucleotide reductase M2 (RRM2) is associated with increased nuclear factor kappa B (NF-kappaB) activity. PMID: 26333382
- our findings establish a signaling role for RRM2 in gastric cancer cells and identify that the RRM2/AKT/NF-kappaB signaling pathway is essential for tumor invasiveness in gastric cancer cells PMID: 27348973
- HBV exploits the Chk1-E2F1 axis of the DNA damage response pathway to induce R2 expression in a cell cycle-independent manner. PMID: 26026873
- High expression level of RRM2 might be negative prognostic factor for resected NSCLC patients. PMID: 26663950
- We suggest that MNNG-stimulated ATR/CHK1 signaling stabilizes E2F3 by S124 phosphorylation, and then E2F3 together with NFY co-transactivate RRM2 expression for DNA repair. PMID: 26921499
- In non-small cell lung cancer, RRM2 expression was predictive of disease-specific survival in women, non-smokers and former smokers. Higher expression was associated with worse survival. This was not the case for men, and current or recently quit smokers. PMID: 26001082
- These results suggested that RRM2 supported the growth of human OSCC cells and that targeting of RRM2, e.g., via GEM treatment, may be a promising therapeutic strategy for OSCC. PMID: 25738429
- Understanding the role of E2F1 in activating RRM2 transcription will help to explain the relationship between E2F1 and RRM2 in colorectal cancer PMID: 26093293
- R2 and p53R2 small subunits are subject to caspase-dependent degradation PMID: 25878246
- Results showed that RRM2 overexpression impacted the survivability of breast cancer patients.[Meta-Analysis] PMID: 25213022
- Our study suggests for evaluating RRM2-associated metabolites as noninvasive markers for tamoxifen resistance PMID: 25016594
- RRM2 is a new molecular marker for the diagnosis and clinical outcomes of cervical cancer. It is involved in cervical carcinogenesis and predicts poor survival. PMID: 24637958
- these findings suggest that RRM2 plays a crucial role in gastric tumorigenesis and may serve as a potential prognostic marker and therapeutic target in gastric cancer. PMID: 24756820
- Data indicate that the expression of ribonucleotide reductase small subunit M2 (RRM2) positively associated with biochemical recurrence of prostate cancer (PCa). PMID: 24360663
- HPVE7 induces upregulation of RRM2, which then promotes cervical carcinogenesis via ROS-ERK1/2-HIF-1alpha-VEGF-induced angiogenesis. PMID: 24423925
- Data indicate that transfection of the wild-type M2 but not the K95E mutant rescued the G1/S phase cell cycle arrest and cell growth inhibition caused by the siRNA knockdown of M2. PMID: 24253041
- RRM2 small interfering RNA-mediated treatment is an effective strategy to inverse chemosensitivity of tumor cells to cisplatin, enhance the efficacy of Gem-induced cytotoxicity and promote apoptosis of cisplatin-resistant ovarian cancer cells in vitro. PMID: 23466567
- Our novel findings add to the knowledge of RRM2 in regulating expression of the antiapoptotic protein Bcl-2 and reveal a critical link between RRM2 and Bcl-2 in apoptosis signaling. PMID: 23719266
- p21-mediated RNR2 repression restricts HIV-1 replication in macrophages by inhibiting dNTP biosynthesis pathway. PMID: 24082141
- The crystal structure of RRM1/2 complexed with target mRNA has been solved; comparison of the two structures show that RNA-binding protein RRM1/2 undergoes conformational changes upon RNA binding. PMID: 23519412
- RRM2 was found to be a key determinant of both inherent and acquired gemcitabine with reduced let-7 expression likely to contribute to RRM2-mediated inherent chemoresistance in poorly differentiated pancreatic cancer cells. PMID: 23335963
- RRM2 may be a facilitating factor in colorectal tumorigenesis and UV-induced DNA damage repair. PMID: 23002339
- High tumor expression of RRM2 and ERCC1 are associated with reduced recurrence free survival and overall survival after resection of pancreas cancer. PMID: 22569992
- RRM2 expression closely correlates with the development of ovarian tumor and may serve as a novel predictive marker for diagnosis and prognosis of the disease. PMID: 22884145
- After DNA damage, cyclin F is downregulated in an ATR-dependent manner to allow accumulation of RRM2. Defective elimination of cyclin F delays DNA repair and sensitizes cells to DNA damage, a phenotype that is reverted by expressing a nondegradable RRM2 mutant. PMID: 22632967
- RRM2 protein expression in pancreatic adenocarcinoma is neither prognostic nor predictive of adjuvant gemcitabine benefit in patients with resectable pancreatic adenocarcinoma. PMID: 22670179
- Recombinant RRM2 translocates from the cytoplasm to the nucleus in a time-dependent manner, leading to stabilization of urokinase mRNA. Overexpression of RRM2 inhibits urokinase protein and mRNA expression through destabilization of uPA mRNA. PMID: 22166006
- Knockdown of the ribonucleotide RR2 subunit leads to decreased cisplatin-induced gap-filling synthesis in nucleotide excision repair and a reduced 2'-deoxyadenosine triphosphate (dATP) level in the G2/M phase of the cell cycle. PMID: 21875941
- HDM-2 inhibition suppresses expression of ribonucleotide reductase subunit M2, and synergistically enhances gemcitabine-induced cytotoxicity in mantle cell lymphoma. PMID: 21844567
- p53R2 expression seems more important than that of hRRM2 in prognosis of early-stage lung cancer. PMID: 21965764
- Under serum-starved conditions, the expression level of RRM2 protein increased in HCT116 cells compared to HKe3 cells (HCT116 cells with a disruption in oncogenic KRAS), and the re-expression of KRAS in HKe3 cells induced the expression of RRM2. PMID: 21873171
- We have shown frequent overexpression of RRM2 protein and its possible role in bladder cancer. PMID: 21166702
- High RRM2 is associated with gemcitabine resistance in pancreatic cancer. PMID: 20927319
- Ribonucleotide reductase M2 subunit overexpression could be associated with the gastric cancer progression. PMID: 20825972
- This study correlates the distinct catalytic mechanisms of the small subunits hp53R2 and hRRM2 with a hydrogen-bonding network. PMID: 20484015
顯示更多
收起更多
-
亞細胞定位:Cytoplasm. Nucleus.
-
蛋白家族:Ribonucleoside diphosphate reductase small chain family
-
數據庫鏈接:
Most popular with customers
-
-
Phospho-YAP1 (S127) Recombinant Monoclonal Antibody
Applications: ELISA, WB, IHC
Species Reactivity: Human
-
-
-
-
-
-